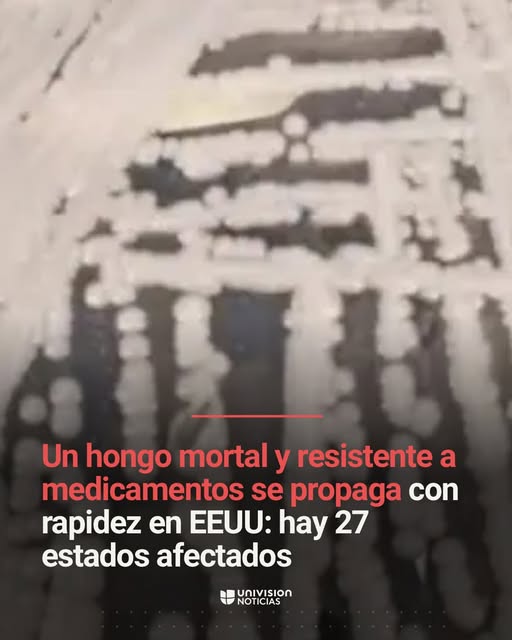
Image

¿Alerta en EEUU por la propagación de un hongo mortal y resistente a medicamentos en 27 estados?
This content has been submitted by users and has not yet been investigated by our team.
You can collaborate by providing clues.
«Alerta en EEUU por la propagación de un hongo mortal y resistente a medicamentos en 27 estados»
This content has been submitted by users and has not yet been investigated by our team